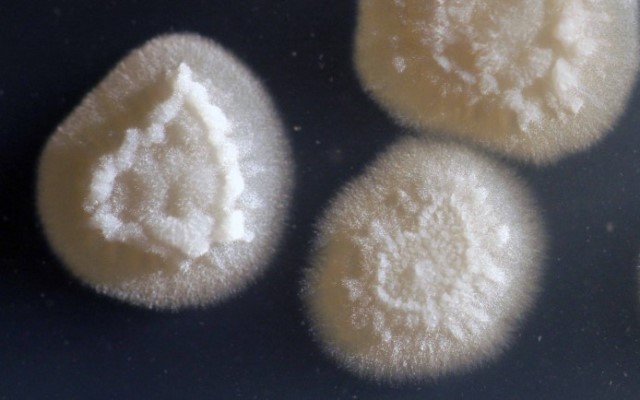

Zjedz jabłko, a najlepiej je... wypij
Od dzieciństwa słyszymy, że jedzenie jabłek sprzyja naszemu zdrowiu. Dzięki badaniom przeprowadzonym na wrocławskim Uniwersytecie Przyrodniczym pod kierunkiem prof. Jana Oszmiańskiego z Zakładu Technologii Owoców i Warzyw, okazuje się, że ten dobroczynny wpływ jabłek może być większy zależnie od formy, w jakiej te owoce spożywamy. Naukowcy dowiedli bowiem, że najlepszy jest mętny sok jabłkowy – wzmacnia organizm i zapobiega jego starzeniu się, a także rozwojowi nowotworów, bo zawiera cztery razy więcej flawonoidów – które m.in. mają silne działanie przeciwnowotworowe, przeciwzapalne, przeciwalergiczne i pochłaniają szkodliwe promieniowanie UVA i UVB – niż soki klarowne. Badania trwały ok. trzech lat, a ich przedmiotem stały się szczególnie dwie odmiany smacznych owoców – idared i szampion. (fot. ilustracyjna: pixabay)

Nie tylko żółtko, czyli wielka moc kurzego białka
To zespół wrocławskich naukowców, kierowanych przez prof. Macieja Siewińskiego z Zakładu Nauk Podstawowych wówczas jeszcze Akademii Medycznej we Wrocławiu (2007 r.), jako pierwszy na świecie opatentował prostą i opłacalną metodę pozyskiwania z kurzego białka substacji hamującej rozwój nowotworów – cystatyny. Gdy sprawa stała się głośna, uczeni uczciwie przyznali, że do odkrycia doszło… przypadkiem. Osoba odpowiedzialna za podłączenie aparatury zrobiła to bowiem nie tak, jak należy, co jednak, paradoksalnie, bardzo pomogło naukowcom w odkryciu. Co ciekawe, np. Amerykanie musieli zrezygnować z pozyskiwania czystej cystatyny, bo ich metoda okazała się za droga – 1 miligram kosztował ok. 300 euro. Wrocławianie podobną ilość preparatu uzyskali za kilkanaście euro i to za sprawą bardziej wydajnej metody. (fot. ilustracyjna: pixabay)

Mały pasożyt już się nie ukrywa
Kilka lat temu (200 7 r.) wrocławscy naukowcy z Zakładu Parazytologii Uniwersytetu Wrocławskiego – Joanna Hildebrand, Jerzy Okulewicz i Marcin Popiołek – odkryli coś, co stało się sensacją biologiczną na skalę światową. Chodzi o Brachylecithum glareoli, czyli bezkręgowca, niewielkiego (2-8 mm) pasożyta, tzw. przywrę, żerującego na gryzoniach. Na jego ślad natrafiono, badając nornice rude na wrocławskich terenach wodonośnych. Pasożyt żyje w przewodach żółciowych tych gryzoni i nie jest niebezpieczny dla ludzi. Odkrycie odbiło się szerokim echem w świecie nauki, ponieważ sądzono, że na obszarze Europy nie ma już nieznanych gatunków. Tym większa więc zasługa zoologów z Wrocławia. W wyniku konkursu, odkryty bezkręgowiec – zgodnie z miejscem pochodzenia – został nazwany wrobakiem. (fot: Brachylecithum glareoli, terrarium.pl)
W Ameryce żują gumę o wrocławskim „posmaku”
Prof. Antoni Polanowski, biochemik z Uniwersytetu Wrocławskiego, koordynował badania, prowadzone na UWr, w Instytucie Immunologii i Terapii Doświadczalnej PAN oraz na wówczas Akademii Medycznej, nad niezwykłym preparatem – kolostryniną. Wykazano, że spowalnia ona przebieg choroby Alzheimera, zwłaszcza na jej wczesnym etapie, poprawiając pacjentowi pamięć, koncentrację i nastrój. Wrocławski wynalazek trafił (2007 r.) do produkcji w USA i Kanadzie (w zamian za sfinansowanie badań naukowcy z Wrocławia sprzedali prawa do własności intelektualnej), a zastosowano go w dostępnej na receptę… czekoladowej gumie do żucia, ponieważ w takiej formie preparat najlepiej dobrze się wchłania. (fot. ilustracyjna: pixabay)
Opijając się paliwem, czyszczą glebę
Na wrocławskim Uniwersytecie Przyrodniczym zespół badaczy pod kierunkiem prof. Małgorzaty Robak wykorzystał drożdże z gatunku Yarrowia lipolytica, które są używane np. w dojrzewaniu serów pleśniowych, do opracownia prostej metody usuwania ropopochodnych zanieczyszczeń z gleby. Jak to działa, naukowcy sprawdzili na terenie bazy paliwowej po Armii Radzieckiej w Bornem Sulinowie, której bardzo skażony teren oczyszczali drożdżami w postaci płynnej i w formie granulek. Te drugie wprowadzili do nawierconych otworów, dowodząc, że granulki lepiej sprawdzają się w walce z ropą, a aktywne są jeszcze po dwóch latach. Kilka miesięcy wystarczyło również, by zanieczyszczenie terenu znacznie się zmniejszyło. Półtora kilograma niezwykłych drożdży potrafi usunąć toksyny z paliw z powierzchni hektara do metra w głąb ziemi. (fot. Yarrowia lipolytica, microbialfoods.org)

Sprawny uścisk sztucznej dłoni
Dzięki temu wynalazkowi, osoba, która straciła własną rękę nie musi rezygnować z wykonywania wielu podstawowych czynności, jak trzymanie przedmiotów, golenie się, otwieranie książki czy nawet prowadzenie samochodu. Na Politechnice Wrocławskiej, w Zakładzie Inżynierii Biomedycznej i Mechaniki Eksperymentalnej, jego szef prof. Romuald Będziński wespół z dr. Krzysztofem Krysztoforskim opracowali (2011 r.) pierwszy w Polsce prototyp protezy dłoni, sterowany impulsami elektrycznymi lub akustycznymi, płynącymi z mięśni. Konstrukcję, nad którą pracowano przez trzy lata, wykonano z aluminium, plastiku i stali i wiązki przewodów. Jest ona montowana do modelowanej na miarę nakładki, która ma elektrody dociśnięte za pomocą sprężynek do uciętego mięśnia – ponad nadgarstkiem, do kikuta przedramienia. Proteza jest poruszana siłą woli – pomimo amputacji sygnały z układu nerwowego nadal płyną z mózgu przez rdzeń kręgowy aż do mięśni szkieletowych, elektrody ze sztucznej dłoni zbierają impulsy elektryczne z ruchu mięśni, przekazują je do mikroprocesora, który steruje silnikiem, i do trzech zębatych przekładek zębatych. One wprawiają w ruch aluminiowe palce: kciuk, wskazujący i środkowy. Mały i serdeczny palec są puste. Trzypalczasta proteza jest zdaniem uczonych łatwiejsza w treningu dla pacjentów. No i ta z pięcioma palcami jest zdecydowanie droższa. (fot.: Prototyp protezy dłoni, Politechnika Wrocławska)

Niedaleko kury – jaja doskonałe, co żywią i leczą
Badacze z wrocławskiego Uniwersytetu Przyrodniczego zaangażowali się w projekt pn. „Ovocura” (2009-2013), koordynowany przez prof. Tadeusza Trziszkę. Jego celem było uzyskanie nowej generacji jaj, wzbogaconych m.in. witaminami i kwasami tłuszczowymi omega-3, tak by wytwarzać z nich preparaty, możliwe do wykorzystania do prewencji i leczenia chorób cywilizacyjnych. W pracę nad tym dziełem zaangażowanych było ponad 230 osób. Jak tworzono jaja doskonałe? Znoszące je kury i przepiórki były karmione m.in. substancjami pochodzącymi z alg, w odpowiednich warunkach środowiskowych. Dzięki temu jaja wzbogacono o bioaktywne substancje, w tym witaminy oraz wielonienasycone kwasy tłuszczowe – zwłaszcza DHA, który mają wpływ na właściwą pracę mózgu, serca czy układu krążenia. Potem z tych jaj udało się uzyskać różne preparaty, w tym fosfolipidy, decydujące o właściwym funkcjonowaniu wspomnianych narządów, do użycia w różnych suplementach diety. Można je stosować m.in. w leczeniu nadciśnienia, terapii schorzeń centralnego układu nerwowego, w tym choroby Alzheimera, a także depresji, miażdżycy i osteoporozy. (fot. ilustracyjna: pixabay)

„Gąsienica” bada liny i nie spada
„Linołazem” albo „gąsienicą” nazywają potocznie swój wynalazek inżynierowie z Politechniki Wrocławskiej – prof. Piotr Dudziński i mgr inż. Adam Konieczny z Wydziału Mechanicznego. Jego fachowa nazwa zaś to: mechatroniczny pojazd gąsienicowy. Przeznaczony jest do serwisowania lin, zabezpieczających wysokie obiekty, takie jak stalowe komy, mosty czy maszty antenowe, do których dotarcie na całej ich długości bywało czasami wręcz niemożliwe. Ze względu na brak urządzenia, które dałoby radę wspiąć się po wysmarowanej towotem powierzchni. Prace nad „linołazem” trwały dwa lata. Powstała (2012 r.) 80-kilogramowa maszyna z napędem na cztery koła, która jako pierwsza na świecie może poruszać się po mocno nachylonych (co najmniej pod kątem 65 st.) linach pokrytych smarem. Bez obawy o uszkodzenia, może ona również samoczynnie pokonywać napotkane przeszkody – złącza linowe, wsporniki czy izolatory, a każdy ruch urządzenia jest nagrywany kamerką, podgląd zaś od razu trafia do komputerów. Dzięki temu obsługujący „gasienicę” może na bieżąco śledzić każdy fragment badanej liny. (fot. „Linołaz”, Politechnika Wrocławska)

Mają nosa do stawiania ludzi na nogi
O tej eksperymentalnej operacji, którą przeprowadzono w Klince Neurochirurgii Uniwersyteckiego Szpitala Klinicznego we Wrocławiu, usłyszał cały świat. Dzięki metodzie opracowanej przez zespół lekarzy z Kliniki oraz z Instytutu Immunologii i Terapii Doświadczalnej Polskiej Akademii Nauk, kierowany przez dr. Pawła Tabakowa i prof. Włodzimierza Jarmundowicza, przy współpracy brytyjskich specjalistów, udało się dosłownie postawić na nogi sparaliżowanego pacjenta. Mężczyzna ten, na skutek ataku z użyciem noża, miał prawie całkowicie przerwany rdzeń kręgowy. Nowatorska operacja, którą przeszedł, polegała na wszczepieniu mu do rdzenia kręgowego fragmentów jego własnych nerwów oraz komórki tzw. gleju węchowego. To one w mózgu odżywiają neurony odpowiedzialne za węch. Po dwóch latach od operacji, do której doszło w 2012 r., pacjent był już w stanie postawić za pomocą chodzika pierwsze kroki, a także kontrolować ruchy nóg. W tym przypadku powiedzenie, że cuda w medycynie się zdarzają, ma zupełnie „niemistyczny” wymiar… (fot. ilustracyjna)

„Jurek” obierze kierunek za ciebie
Jak to jest, gdy siedząc za kierownicą samochodu, nie trzeba właściwie wykonywać żadnych ruchów, żeby pojazd się poruszał – pokazali w 2013 r. twórcy pierwszego w Polsce autonomicznego samochodu, czyli studenci Wydziału Mechanicznego Politechniki Wrocławskiej. „Cześć, mówi twój najlepszy kierowca Jurek” – to usłyszy pasażer od komputera, który steruje pojazdem skonstruowanym przez młodych inżynierów. Jurek więc sobie jedzie, a kierowca z krwi i kości może w tym czasie w zasadzie trzymać ręce w kieszeniach, bo samochód sam doskonale radzi sobie na wyznaczonej trasie. Zależnie od tego, co „widzi” przed sobą, wykonując polecenia komputera, potrafi wydedukować, którędy ma jechać, z taką prędkością, jaka będzie mu zadana. Potrafi oczywiście skręcać i hamować. A co najlepsze, w wyglądającym jak typowe aucie nie trzeba wcale siedzieć, żeby wprawić je w ruch. Można to zrobić przez internet z komputera znajdującego się nawet na innym kontynencie. (fot.: Jurek na trasie, Politechnika Wrocławska)

Tak to z cudownym lnem było...
Przyjrzeli się mu bliżej biochemicy z Uniwersytetu Wrocławskiego pod kierunkiem prof. Jana Szopy-Skórkowskiego, a potem len zmodyfikowali genetycznie tak, że zrobione z niego ubrania nie gniotą się i nie moczą, a plastry przyspieszają gojenie ran, dodany zaś do tworzyw sztucznych sprawia, że szybciej ulegają one rozkładowi. Jak mówili badacze, cudowny len powstał dzięki wrpowadzeniu do jego włókien genów grzybów z rodziny Aspergillus, a także pewnych roślin z Ameryki Południowej. Informacja o niezwykłych właściwościach pospolitej rośliny, „spreparowanej” w naukowym laboratorium, gruchnęła w 2008 r. i wszyscy byli zachwyceni, że z wrocławskiego lnu można otrzymać m.in. nici chirurgiczne i opatrunki na skaleczenia, oparzenia, infrekcje albo do ochrony albo do ochrony pola operacyjnego. A potem zaczęły się schody z komercjalizacją tego wynalazku. Firmy farmaceutyczne w Polsce, nie wiedzieć czemu, nie prześcigały się w propozycjach wprowadzenia niezwykłego materiału na rynek, blokowano również środki na dalsze badania. Sprawa zaczęła nabierać rumieńców w zasadzie w ub. roku. Ale to już temat na nieco dłuższą „bajkę”... (fot. ilustracyjna: Pinterest)
